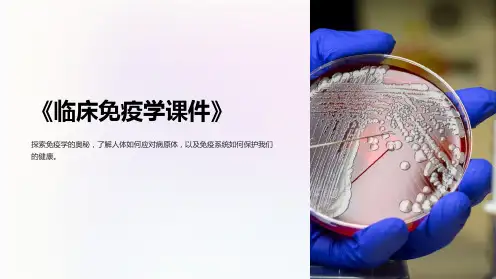

临床免疫学课件
- 格式:ppt
- 大小:3.00 MB
- 文档页数:67




临床免疫学与检验培训课件xx年xx月xx日•临床免疫学基础知识•临床检验技术概述•免疫学检验技术及应用目录•临床免疫学与检验案例分析•总结与展望01临床免疫学基础知识免疫器官免疫细胞免疫分子T细胞、B细胞、NK细胞、巨噬细胞等。
抗体、补体、细胞因子等。
03免疫系统的组成与功能02 01胸腺、骨髓、淋巴结、脾脏等。
免疫细胞对外部抗原进行识别并作出反应。
抗原识别免疫细胞活化并分化为效应细胞和记忆细胞。
活化与分化效应细胞发挥免疫效应,清除抗原。
效应功能免疫应答的基本过程免疫学在医学诊断与治疗中的应用通过检测抗体或抗原检测感染。
感染诊断疫苗开发自身免疫性疾病治疗肿瘤免疫治疗基于免疫学原理开发疫苗。
利用免疫抑制剂、抗炎药物等治疗自身免疫性疾病。
利用肿瘤免疫疗法治疗肿瘤。
02临床检验技术概述临床检验的基本概念与分类01临床检验是指通过运用各种检验技术,对患者的血液、体液、分泌物、排泄物、细胞组织等进行检验,以获得客观准确的检验结果,为临床诊断、治疗和预后评估提供依据。
02临床检验技术可根据检验对象和检验目的的不同,分为血液检验、尿液检验、粪便检验、分泌物检验、细胞组织病理学检查等。
03各种检验技术都有其特定的应用范围和适用条件,临床医生应根据患者的病情和诊断需要,选择合适的检验项目和检验技术。
临床检验的流程包括患者准备、标本采集、标本处理、检验操作、结果分析和报告等环节。
在患者准备环节,应告知患者检验前注意事项,如饮食、休息、停药等。
在标本采集环节,应根据检验项目的要求,选择合适的标本类型和采集方法。
在标本处理和检验操作环节,应遵循实验室安全规范和质量控制标准,确保检验结果的准确性和可靠性。
在结果分析和报告环节,应对检验结果进行审核和校对,确保结果的准确性和完整性。
临床检验的流程与规范临床检验的质量控制包括实验室内质量控制和实验室间质量控制。
实验室间质量控制是指在不同实验室之间进行的质控活动,包括参加外部质量评价计划、比对试验等。